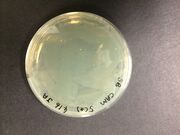
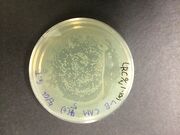
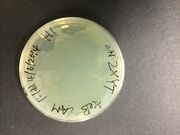
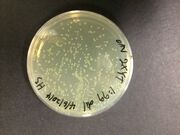

Uploads by Raul M. Cuellar
From OpenWetWare
Jump to navigationJump to search
This special page shows all uploaded files.
| Date | Name | Thumbnail | Size | Description |
|---|---|---|---|---|
| 11:53, 12 June 2014 | OD values.jpg (file) | 54 KB | ||
| 11:50, 12 June 2014 | OD dilution values.png (file) |  |
23 KB | |
| 11:50, 12 June 2014 | NanoDrop readout.png (file) |  |
11 KB | |
| 11:49, 12 June 2014 | Nanod R.jpg (file) |  |
11 KB | |
| 11:47, 12 June 2014 | OD600 values.jpg (file) | 54 KB | ||
| 14:25, 10 June 2014 | Plan.jpg (file) |  |
76 KB | |
| 10:46, 7 June 2014 | Broth Recipe.png (file) |  |
16 KB | |
| 10:09, 7 June 2014 | Tubes.png (file) |  |
175 KB | |
| 09:44, 7 June 2014 | Plates 1.png (file) |  |
229 KB | |
| 06:10, 7 June 2014 | SB fresh medium.JPG (file) |  |
1.78 MB | |
| 06:10, 7 June 2014 | Overnight SB medium.JPG (file) |  |
1.93 MB | |
| 06:10, 7 June 2014 | Overnight SB DH10B.JPG (file) |  |
1.99 MB | |
| 06:10, 7 June 2014 | Overnight SB AceB dil100.JPG (file) | |
1.84 MB | |
| 06:10, 7 June 2014 | Overnight SB AceB dil2.JPG (file) |  |
1.75 MB | |
| 06:08, 7 June 2014 | Overnight LB medium.JPG (file) |  |
1.8 MB | |
| 06:08, 7 June 2014 | Overnight LB DH10B.JPG (file) |  |
1.86 MB | |
| 06:08, 7 June 2014 | Overnight LB AceB dil100.JPG (file) | |
1.85 MB | |
| 06:08, 7 June 2014 | Overnight LB AceB dil2.JPG (file) |  |
1.78 MB | |
| 06:08, 7 June 2014 | Overnight 2xYT medium.JPG (file) |  |
1.53 MB | |
| 06:07, 7 June 2014 | Overnight 2xYT DH10B.JPG (file) |  |
1.86 MB | Overnight 2xYT DH10B |
| 06:07, 7 June 2014 | Overnight 2xYT AceB dil2.JPG (file) | |
1.71 MB | Overnight 2xYT AceB dil2 |
| 06:07, 7 June 2014 | Overnight 2xYT AceB dil100.JPG (file) | |
1.63 MB | Overnight 2xYT AceB dil100 |
| 06:07, 7 June 2014 | LB fresh medium.JPG (file) |  |
1.74 MB | LB fresh medium |
| 06:07, 7 June 2014 | 2xYT fresh medium.JPG (file) |  |
1.72 MB | 2xYT fresh medium |
| 14:56, 6 June 2014 | Super b M.jpg (file) | 28 KB | ||
| 14:55, 6 June 2014 | LB medium .jpg (file) | 26 KB | ||
| 14:54, 6 June 2014 | 2xYT M.jpg (file) | 29 KB | ||
| 14:42, 6 June 2014 | What is Life(Erwin Schöerdinger).pdf (file) |  |
44 KB | |
| 14:39, 6 June 2014 | Contact list (iGEM 2014).xlsx (file) | 11 KB | ||
| 14:30, 6 June 2014 | Optical Density Readings.xlsx (file) | 13 KB |